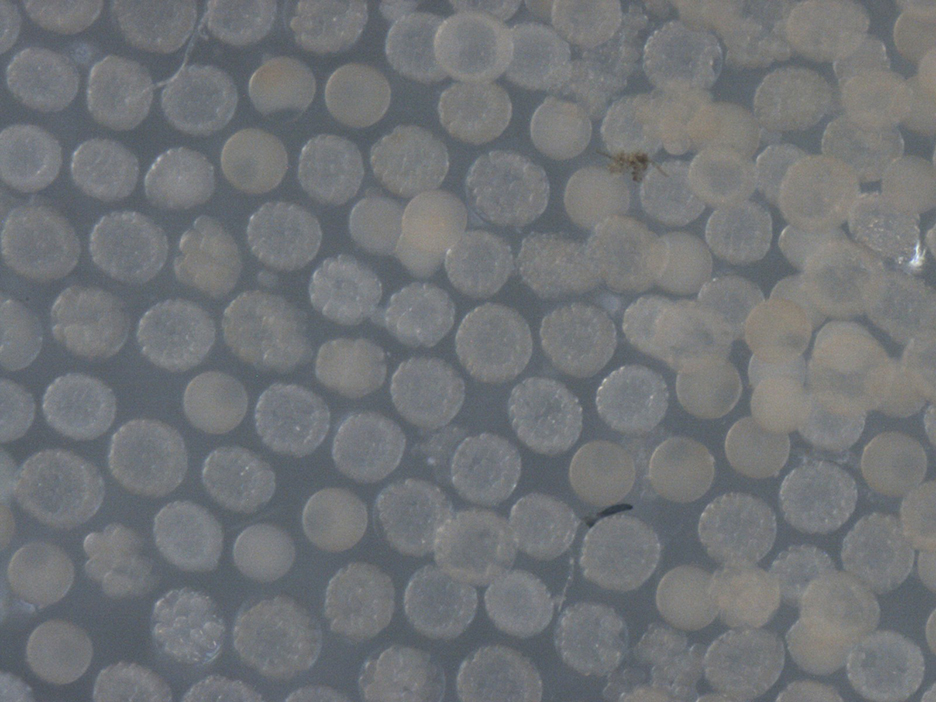

The Beach Experience Hall stands alongside the Enoshima Aquarium that is located opposite Enoshima Island, where it is said that the first marine biological laboratory was established in Japan. At the Beach Experience Hall, you are encouraged to think and act based on what you have learned about the seashore located on the border between land and the ocean. Nikon's microscopes help enable visitors of all ages to observe marine life.
The ocean covers approximately 70% of the earth's surface. Japan has one of the longest coastlines in the world.
The total surface area of the earth is about 510 million km2. Across that vast area, approximately 360 million km2 is occupied by the ocean. In other words, about 70% of the earth's surface is comprised of ocean. This "vast size of the ocean" is the main reason why the earth is called a blue planet. The ocean is regarded as the source of life on earth, and is also one of the primary sources of weather and atmospheric circulation that produces clouds, wind and rain across our planet.


Japan is an island nation surrounded by the ocean on all sides. The total length of the Japanese coastline is about 34,000 km. This is a distance close to 40,000 km, which is the approximate circumference of the earth. In addition, a number of ocean currents flow through water adjacent to Japan, which collectively support biodiversity in this area.
According to "Marine Biodiversity in Japanese Waters" research (2010) created by the Japan Agency for Marine-Earth Science and Technology, along with groups such as Kyoto University and the University of Tokyo, about 34,000 species, including bacteria, fish, mammals and deep-sea creatures, dwell in the habitat surrounding Japan. This marine habitat is one of the richest in the world - comparable to that of Australia.
The Enoshima Aquarium is located in Kanagawa prefecture which contains Sagami Bay. The basic theme of the aquarium is to display, collect and research marine life from Sagami Bay and the Pacific Ocean. As an edutainment*1 aquarium, the Enoshima Aquarium provides you with the enjoyable experience of learning about the ocean and surrounding environments through exhibitions, shows and experiential programs.


The deepest part of Sagami Bay reaches 1,000 m. Seawater from the Kuroshio current system flows in the surface layer and currents from the Oyashio system flow in the deep layer. River water from the Tanzawa and Hakone forests blends into the bay which provides rich, nutritious water quality and approximately 1,000 species of fish. Sagami Bay is one of the richest sea areas and can be called a treasure trove of sea creatures. By opening the world's first jellyfish exhibition hall and exhibiting valuable deep-sea creatures, the Enoshima Aquarium has been a frontrunner in groundbreaking events in the aquarium industry since its predecessor aquarium period. Additionally, the "Night Aquarium" was successfully implemented in 2014 as the first in Japan to introduce a full-scale projection mapping exhibition in the aquarium industry and it also successfully exhibited the world's first living "shirasu" (young sardines). These developments may not be extraneous to the fact that renowned American zoologist Edward S. Morse is said to have founded Japan's first marine biological laboratory in Enoshima back in 1877*2.
- *1Edutainment is a compound word of education and entertainment. Recently, it is recognized as a term describing a method of learning while enjoying a visit to a museum or art gallery.
- *2 Edward S. Morse rented a hut on Enoshima Island and conducted marine biological studies, but the address of the facility has not been recorded.
Access to Enoshima Aquarium
- 3 min. walk from Katase-Enoshima Station on the Odakyu Line
- 10 min. walk from Enoshima Station on the Enoden Line
- 10 min. walk from Shonan-Enoshima Station on the Shonan Monorail Line
- *Some parts of the exhibitions are temporarily closed.


The Beach Experience Hall, adjacent to the Enoshima Aquarium, facilitates learning about the Shonan seashore
The blue building standing close to the Enoshima Aquarium is the Beach Experience Hall, managed by Kanagawa prefecture. Admission is free for both children and adults. It is connected to the Enoshima Aquarium on the second floor and you are allowed to leave and re-enter if you have an aquarium ticket.


Mai Kasamatsu
Chief Curator of Experiential Learning Mai Kasamatsu explains, "The Beach Experience Hall is where you can interact with the Shonan seashore and learn about its importance, which will help facilitate you to think and act. Based on this theme, we plan various events and exhibitions." This building has two stories, the first floor being the Shonan Discovery Zone and the second floor featuring the Shonan Experience Zone.
At the Shonan Discovery Zone, there is a "Beach explore" section where you can find information about fun activities on the beach and nature observation. There is also a Workshop Lab where you can enjoy making handcrafted projects using shells, stones, beach drifts and recycled products.
At the Shonan Experience Zone, there is a section called "Living Creatures on the Seashore" with aquariums reproducing habitats of creatures that live along the seashore. In the rocky water tank, which reproduces a tidal pool of rocky shores, tidal flats and seaweeds, you can actually touch hermit crabs and starfish. In addition, it introduces a mechanism that creates a tombolo (sandbar connecting the shore with an island) due to the breaking waves. It also displays various drifting objects carried by the ocean current and demonstrates how to curtail sea breezes and flying sand.





The Beach Experience Hall is open year-round* and anyone can visit during the opening hours*. The hall is especially popular for handcrafted projects at the Workshop Lab. Touching hermit crabs and starfish in the rocky water tank at the "Living Creatures on the Seashore" section and a device that lets you experience sand drifting which is unique to the seashore are also popular. All visitors, from children to adults, will find surprises and make discoveries. "We are always excited about what we do and plan various programs including workshops such as handcrafts and seashore field-workshops along with various exhibitions. We then carry out programs and operate the hall to our best ability," Mai explains. Indeed, everyone who visits can be guaranteed to have an exciting time.
- *Open year-round (However, the aquarium is sometimes temporarily closed for facility inspections.)
Opening hours
March to November: 9:00 to 17:00
December to February: 10:00 to 17:00
- *Some parts of the exhibitions are temporarily closed.
Microscopes help us observe the small world of living things.
Nikon's microscopes play an especially active role within the "A Small World" corner of the Shonan Experience Zone. A stereo microscope is placed on a large counter, introducing a mysterious world that cannot be seen with the naked eyes. The observation subject is set on the microscope stage, then the microscope image is displayed on the monitor. Next, Mai and the staff give explanations while watching the monitor with visitors. On this particular day, Hemicentrotus pulcherrimus, a species of sea urchin, was on the monitor. As a strange image appeared on the monitor, Mai softly asked the children present, "Did you know that a sea urchin has feet and claws?" Looking at the part of the monitor she pointed to, countless feet with tips like suction cups, some with shapes like tiny scissors, could be seen here and there. Sea urchins look like they don't move much, but it was surprising to see such lively movement with the help of microscope magnification.



Photo courtesy: The Beach Experience Hall

Photo courtesy: The Beach Experience Hall
Photo courtesy: The Beach Experience Hall

Photo courtesy: The Beach Experience Hall


"It's part of the fun of using a microscope - experiencing the small world of living things that you could never see or know from an everyday viewpoint," Mai explains. Depending on the season, starfish, sea hares or crustacean larvae just hatched from eggs may play a leading role in the discoveries. She expanded on ideas of new ways to utilize a microscope: "We are thinking of showing visitors the process of how sea creatures hatch from the egg state and grow".
"In the future, our staff members will conceptualize and then develop new projects, fun programs and fresh exhibitions that will keep both children and adults alike coming back to our facility," she said with a smile as gentle as the ocean waves.
Revealing the tiny world of the sea leads to learning the value of life and the importance of the environment. We believe this education will help children to create a better future.
Nikon's microscopes will continue to support young people to get to know, learn, think and act for the ocean and all of its inhabitants.
- *Some parts of the exhibitions are temporarily closed.
